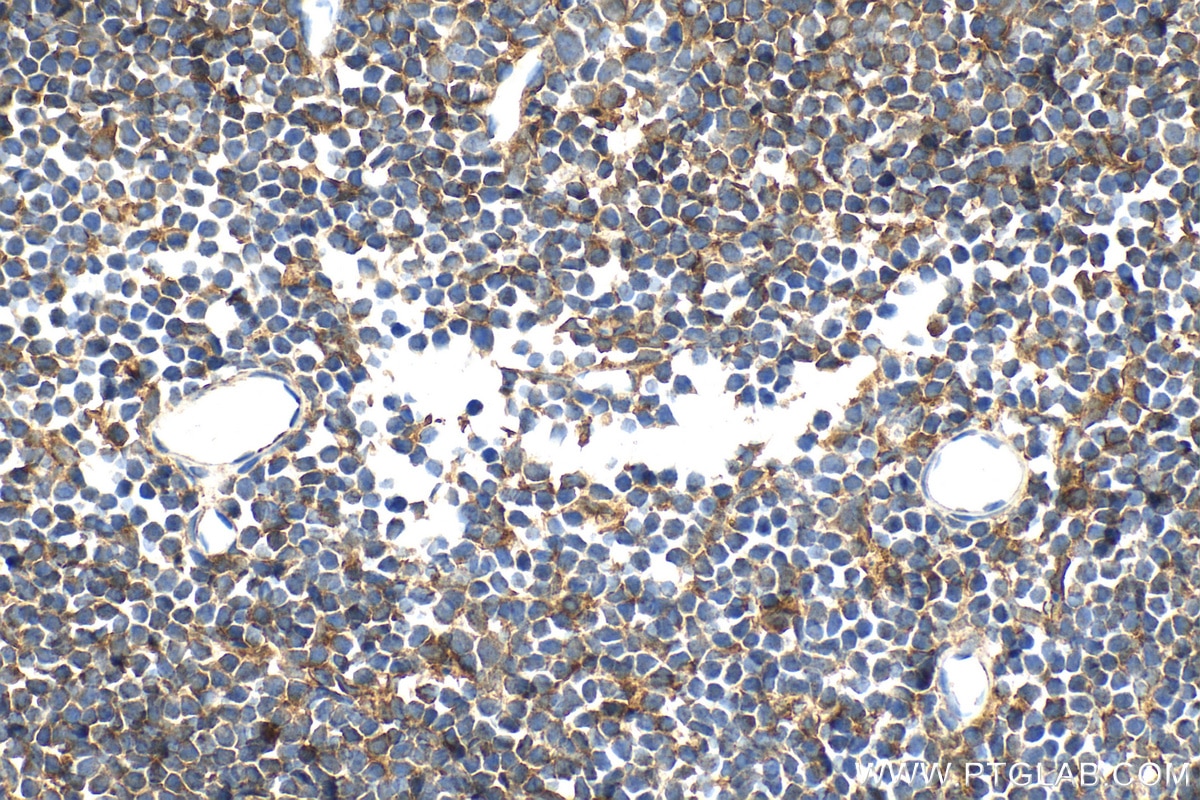
Immunohistochemical analysis of paraffin-embedded mouse spleen tissue slide using 27900-1-AP (MERTK antibody) at dilution of 1:800 (under 40x lens). Immunohistochemistry (IHC) staining of mouse spleen tissue using MERTK Polyclonal antibody (27900-1-AP)

Tested Applications
| Positive WB detected in | HEK-293T cells, U-937 cells, mouse testis tissue, Jurkat cells |
| Positive IHC detected in | rat liver tissue, human lung tissue, mouse lung tissue Note: suggested antigen retrieval with TE buffer pH 9.0; (*) Alternatively, antigen retrieval may be performed with citrate buffer pH 6.0 |
| Positive IF-P detected in | rat liver tissue |
| Positive FC (Intra) detected in | Jurkat cells |
Recommended dilution
| Application | Dilution |
|---|---|
| Western Blot (WB) | WB : 1:500-1:2000 |
| Immunohistochemistry (IHC) | IHC : 1:500-1:2000 |
| Immunofluorescence (IF)-P | IF-P : 1:200-1:800 |
| Flow Cytometry (FC) (INTRA) | FC (INTRA) : 0.25 ug per 10^6 cells in a 100 µl suspension |
| It is recommended that this reagent should be titrated in each testing system to obtain optimal results. | |
| Sample-dependent, Check data in validation data gallery. | |
Published Applications
| WB | See 6 publications below |
| IHC | See 1 publications below |
| IF | See 1 publications below |
Product Information
27900-1-AP targets MERTK in WB, IHC, IF-P, FC (Intra), ELISA applications and shows reactivity with human, mouse, rat samples.
| Tested Reactivity | human, mouse, rat |
| Cited Reactivity | human, mouse |
| Host / Isotype | Rabbit / IgG |
| Class | Polyclonal |
| Type | Antibody |
| Immunogen |
CatNo: Ag27540 Product name: Recombinant human MERTK protein Source: e coli.-derived, PGEX-4T Tag: GST Domain: 829-999 aa of BC114918 Sequence: ELYEIMYSCWRTDPLDRPTFSVLRLQLEKLLESLPDVRNQADVIYVNTQLLESSEGLAQGSTLAPLDLNIDPDSIIASCTPRAAISVVTAEVHDSKPHEGRYILNGGSEEWEDLTSAPSAAVTAEKNSVLPGERLVRNGVSWSHSSMLPLGSSLPDELLFADDSSEGSEVLM Predict reactive species |
| Full Name | c-mer proto-oncogene tyrosine kinase |
| Calculated Molecular Weight | 999 aa, 110 kDa |
| Observed Molecular Weight | 150-180 kDa |
| GenBank Accession Number | BC114918 |
| Gene Symbol | MERTK |
| Gene ID (NCBI) | 10461 |
| RRID | AB_3086006 |
| Conjugate | Unconjugated |
| Form | Liquid |
| Purification Method | Antigen affinity purification |
| UNIPROT ID | Q12866 |
| Storage Buffer | PBS with 0.02% sodium azide and 50% glycerol, pH 7.3. |
| Storage Conditions | Store at -20°C. Stable for one year after shipment. Aliquoting is unnecessary for -20oC storage. 20ul sizes contain 0.1% BSA. |
Background Information
MerTK (Mer tyrosine kinase), also known as RP38, c-Eyk, c-mer, and Tyro12, was first cloned from a human B lymphoblastoid expression library (PMID:8086340) and is one of the TAM (Tyro-3, Axl, and MerTK) receptor tyrosine kinase (RTK) family (PMID:23833304). Although this RTK, like others, can promote tumor cell proliferation to some extent, MERTK primarily lends tumor cells crucial survival advantages while promoting invasion, migration and metastasis, drug resistance, and, in the innate immune system, suppressing anti-tumor immunity (PMID:32417270). The multiple MERTK species observed are likely due to posttranslational modifications (PMID: 23585477).
Protocols
| Product Specific Protocols | |
|---|---|
| FC protocol for MERTK antibody 27900-1-AP | Download protocol |
| IF protocol for MERTK antibody 27900-1-AP | Download protocol |
| IHC protocol for MERTK antibody 27900-1-AP | Download protocol |
| WB protocol for MERTK antibody 27900-1-AP | Download protocol |
| Standard Protocols | |
|---|---|
| Click here to view our Standard Protocols |
Publications
| Species | Application | Title |
|---|---|---|
Cell Rep Med Disruption of MerTK increases the efficacy of checkpoint inhibitor by enhancing ferroptosis and immune response in hepatocellular carcinoma | ||
Front Endocrinol (Lausanne) Downregulation of MerTK in circulating T cells of patients with non-proliferative diabetic retinopathy | ||
Sci Rep Bioinformatics analysis of Rho-signal transduction genes in postmenopausal osteoporosis and periodontitis | ||
Int Immunopharmacol Aβ impairs bone vascular homeostasis in APP/PS1 mice via disrupting the mitochondrial fission-efferocytosis axis in macrophages | ||
Food Sci Nutr Naringenin Accelerates Diabetic Wound Healing via Regulating Macrophage M2 Polarization and Efferocytosis | ||
J Ethnopharmacol Longan Aril polysaccharides ameliorate cognitive impairment in AD mice via restoration of the immune phagocytosis of microglia |